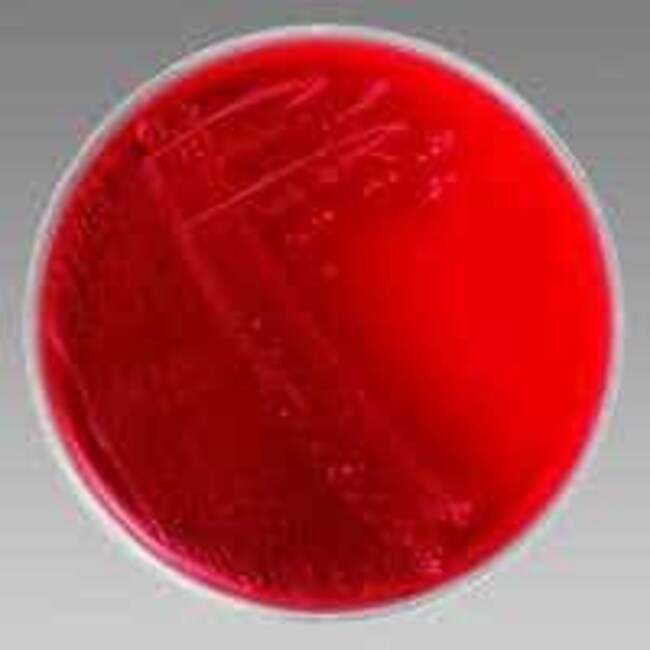
Dermatophyte Test Medium (DTM)

Search
Search
Facilitate selective and differential isolation of pathogenic fungi (dermatophytes) from cutaneous sources using Dermatophyte Test Medium (DTM).
| 货号 | 数量 | 产品规格 |
|---|---|---|
| R10067 | 10/Pk. | 1 oz. Bottle |
Dermatophytes are fungi that possess keratinolytic properties that enable them to invade skin, nails and hair2. The infections caused by these organisms are commonly referred to as ringworm and are classified by the Latin word tinea followed by the area of the body infected3. The dermatophyte test medium (DTM) is recommended for selective isolation of pathogenic fungi from cutaneous sources.
DTM is primarily used as a screening test for detection of dermatophytes. This medium contains soy peptone that supplies the nitrogen and carbon necessary for the growth of microorganisms. Dextrose acts as an energy source. Phenol red is a pH indicator which detects alkaline metabolites produced by dermatophytes, resulting in a color change from yellow to red. The three antibiotics cyclohexamide, chloramphenicol, and gentamycin are selective agents that inhibit growth of certain microorganisms.
Not all products are available for sale in all territories. Please inquire.
Remel™ and Oxoid™ products are now part of the Thermo Scientific brand.
General References: